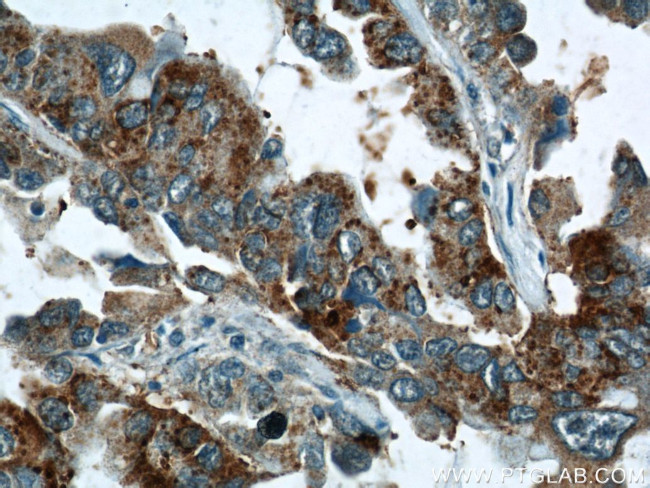
STXBP2 Antibody in Immunohistochemistry (Paraffin) (IHC (P))
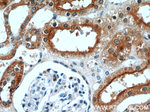
STXBP2 Antibody in Immunohistochemistry (Paraffin) (IHC (P))

Search
Proteintech
STXBP2 Polyclonal Antibody
{{$productOrderCtrl.translations['antibody.pdp.commerceCard.promotion.promotions']}}
{{$productOrderCtrl.translations['antibody.pdp.commerceCard.promotion.viewpromo']}}
{{$productOrderCtrl.translations['antibody.pdp.commerceCard.promotion.promocode']}}: {{promo.promoCode}} {{promo.promoTitle}} {{promo.promoDescription}}. {{$productOrderCtrl.translations['antibody.pdp.commerceCard.promotion.learnmore']}}
产品信息
15312-1-AP
种属反应
已发表种属
宿主/亚型
分类
类型
抗原
偶联物
形式
浓度
规格
纯化类型
保存液
内含物
保存条件
运输条件
产品详细信息
Immunogen sequence: LHELTFQAM AYDLLDIEQD TYRYETTGLS EAREKAVLLD EDDDLWVELR HMHIADVSKK VTELLRTFCE SKRLTTDKAN IKDLSQILKK MPQYQKELNK YSTHLHLADD CMKHFKGSVE KLCSVEQDLA MGSDAEGEKI KDSMKLIVPV LLDAAVPAYD KIRVLLLYIL LRNGVSEENL AKLIQHANVQ AHSSLIRNLE QLGGTVTNPG GSGTSSRLEP RERMEPTYQL SRWTPVIKDV MEDAVEDRLD RNLWPFVSDP APTASSQAAV SARFGHWHKN KAGIEARAGP RLIVYVMGGV AMSEMRAAYE VTRATEGKWE VLIGSSHILT PTRFLDDLKA LDKKLEDIAL P (241-590 aa encoded by BC002869)
靶标信息
This gene encodes a member of the STXBP/unc-18/SEC1 family. The encoded protein is involved in intracellular trafficking, control of SNARE (soluble NSF attachment protein receptor) complex assembly, and the release of cytotoxic granules by natural killer cells. Mutations in this gene are associated with familial hemophagocytic lymphohistiocytosis. Alternatively spliced transcript variants encoding different isoforms have been noted for this gene.
仅用于科研。不用于诊断过程。未经明确授权不得转售。
生物信息学
蛋白别名: Munc18-2; MUSEC1; Protein unc-18 homolog 2; Protein unc-18 homolog B; syntaxin binding protein Munc18-2; Syntaxin-binding protein 2; unc-18 homolog 2; Unc-18B; unc18 homolog; Unc18-2; unnamed protein product
基因别名: C79054; FHL5; Hunc18b; Munc-18-2; Munc-18b; MUNC18-2; Munc18b; muSec1; pp10122; STXBP2; Sxtbp2; Sxtp2; unc-18B; UNC18-2; UNC18B
UniProt ID: (Human) Q15833, (Mouse) Q64324
Entrez Gene ID: (Human) 6813, (Mouse) 20911